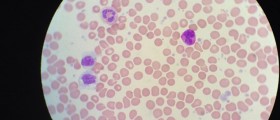

Non-implant Permanent Tooth Replacement: Dental Crowns and Bridges
The popularity of dental implants can sometimes make it feel like they are the only option for permanent teeth replacement. We look at some of the non-implant options that are available readily and the situations they excel in.

Anterior Cruciate Ligament ACL Tear Injury: Causes, Symptoms, Surgery, And ACL Recovery Time
ACL tear injury is very common among athletes and the general population. It is usually caused by a hit to the knee or sudden deceleration. It causes pain, decreased ROM, swelling. ACL tear injury can be treated surgically and conservative.

How To Make Your Own Shea Butter Skin Care Products: Beginners' Recipes
Have you got sensitive skin, do you just prefer knowing what's in your skin care products, or do you like DIY? Here are some fairly easy recipes for shea butter skin care products — moisturizer, hair mask, body lotion, and soap.

Self-Injury Disorder
Self-Injury Disorder (SID) refers to pain or injury intentionally and compulsively inflicted on one's own body without the intent of committing suicide. It is usually present when a person is trying to cope with emotional stress.

Insulin Pump for Type 1 and Type 2 Diabetes
An insulin pump, also known as continuous insulin infusion therapy, can be exactly what insulin-dependent, type 1 diabetics need to keep blood sugar levels under good control. And even some non-insulin dependent, type 2 diabetics also benefit from insulin

Boil Medicine: Signs It's Time To Ask For Antibiotics For Boils (Furuncles)
Boils — nasty, pus-filled, skin infections around hair follicles — are really annoying. They may resolve spontaneously with the help of hot compresses, or with drainage on your doctor's part, but when do you need to ask for antibiotics for boils?

Ten Home Remedies for Kidney Stones: Renal Calculi Treatment
If you have ever had kidney stones, you are not likely to forget the experience.

What Do You Need To Know About Surgery For An ACL Tear Injury?
Not all patients with an ACL tear are candidates for surgery. Minor ALC tears (grade I and II) can be healed with conservative treatment. Grade III ACL tears (complete tears) should be treated surgically.
Essential Thrombocytosis
Chronic myeloproliferative disorders are conditions resulting from the over-accumulation of blood cells.

Rehabilitation Exercises For ACL Tear Injury
Rehabilitation exercises are important for restoring of knee function after ACL tear injuries. The main goal of rehabilitation exercises is to restore knee motion and increase muscle strength which should provide knee stability.